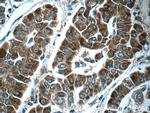
ABL2 Antibody in Immunohistochemistry (Paraffin) (IHC (P))

Search
Proteintech
ABL2 Polyclonal Antibody
{{$productOrderCtrl.translations['antibody.pdp.commerceCard.promotion.promotions']}}
{{$productOrderCtrl.translations['antibody.pdp.commerceCard.promotion.viewpromo']}}
{{$productOrderCtrl.translations['antibody.pdp.commerceCard.promotion.promocode']}}: {{promo.promoCode}} {{promo.promoTitle}} {{promo.promoDescription}}. {{$productOrderCtrl.translations['antibody.pdp.commerceCard.promotion.learnmore']}}
产品信息
17693-1-AP
种属反应
已发表种属
宿主/亚型
分类
类型
抗原
偶联物
形式
浓度
规格
纯化类型
保存液
内含物
保存条件
运输条件
产品详细信息
This protein has 9 isoforms produced by alternative splicing with the molecular weight from 114 kDa to 128 kDa. The antibody is specific to the others except the 60 kDa isoform of ABL2.
Immunogen sequence: SEESAAPSR ERPKAKLLPR GATALPLRTP SGDLAITEKD PPGVGVAGVA AAPKGKEKNG GARLGMAGVP EDGEQPGWPS PAKAAPVLPT THNHKVPVLI SPTLKHTPAD VQLIGTDSQG NKFKLLSEHQ VTSSGDKDRP RRVKPKCAPP PPPVMRLLQH PSICSDPTEE PTALTAGQST SETQEGGKKA ALGAVPISGK AGRPVMPPPQ VPLPTSSISP AKMANGTAGT KVALRKTKQA AEKISADKIS KEALLECADL LSSALTEPVP NSQLVDTGHQ LLDYCSGYVD CIPQTRNKFA FREAVSKLEL SLQELQVSSA AAGVPGTNPV LNNLLSCVQE ISDVVQR (822-1167 aa encoded by BC065912)
靶标信息
ABL2 (Arg) is an Abl-related non-receptor protein tyrosine kinase that links cell surface receptors to cell proliferation and/or cytoskeletal reorganization. Abl2 encodes a member of the Abelson family of nonreceptor tyrosine protein kinase. The protein is highly similar to the ABL1 protein, including the tyrosine kinase, SH2 and SH3 domains, and has a role in cytoskeletal rearrangements by its C-terminal F-actin- and microtubule-binding sequences. Abl2 is expressed in both normal and tumor cells, and is involved in translocation with the ETV6 gene in leukemia. Multiple alternatively spliced transcript variants encoding different protein isoforms have been found for this gene.
仅用于科研。不用于诊断过程。未经明确授权不得转售。
生物信息学
蛋白别名: Abelson murine leukemia viral (v-abl) oncogene homolog 2; Abelson murine leukemia viral oncogene homolog 2; Abelson tyrosine-protein kinase 2; Abelson-related gene protein; Abl1-related gene product; abl2; arg tyrosine kinase; c-abl oncogene 2, non-receptor tyrosine kinase; FLJ22224; FLJ31718; FLJ41441; tyrosine kinase ARG; Tyrosine-protein kinase ABL2; Tyrosine-protein kinase ARG; v-abl Abelson murine leukemia viral oncogene 2; v-abl Abelson murine leukemia viral oncogene homolog 2; v-abl Abelson murine leukemia viral oncogene homolog 2 (arg, Abelson-related gene)
基因别名: AA536808; ABL2; ABLL; ARG
UniProt ID: (Human) P42684
Entrez Gene ID: (Human) 27, (Mouse) 11352, (Rat) 304883